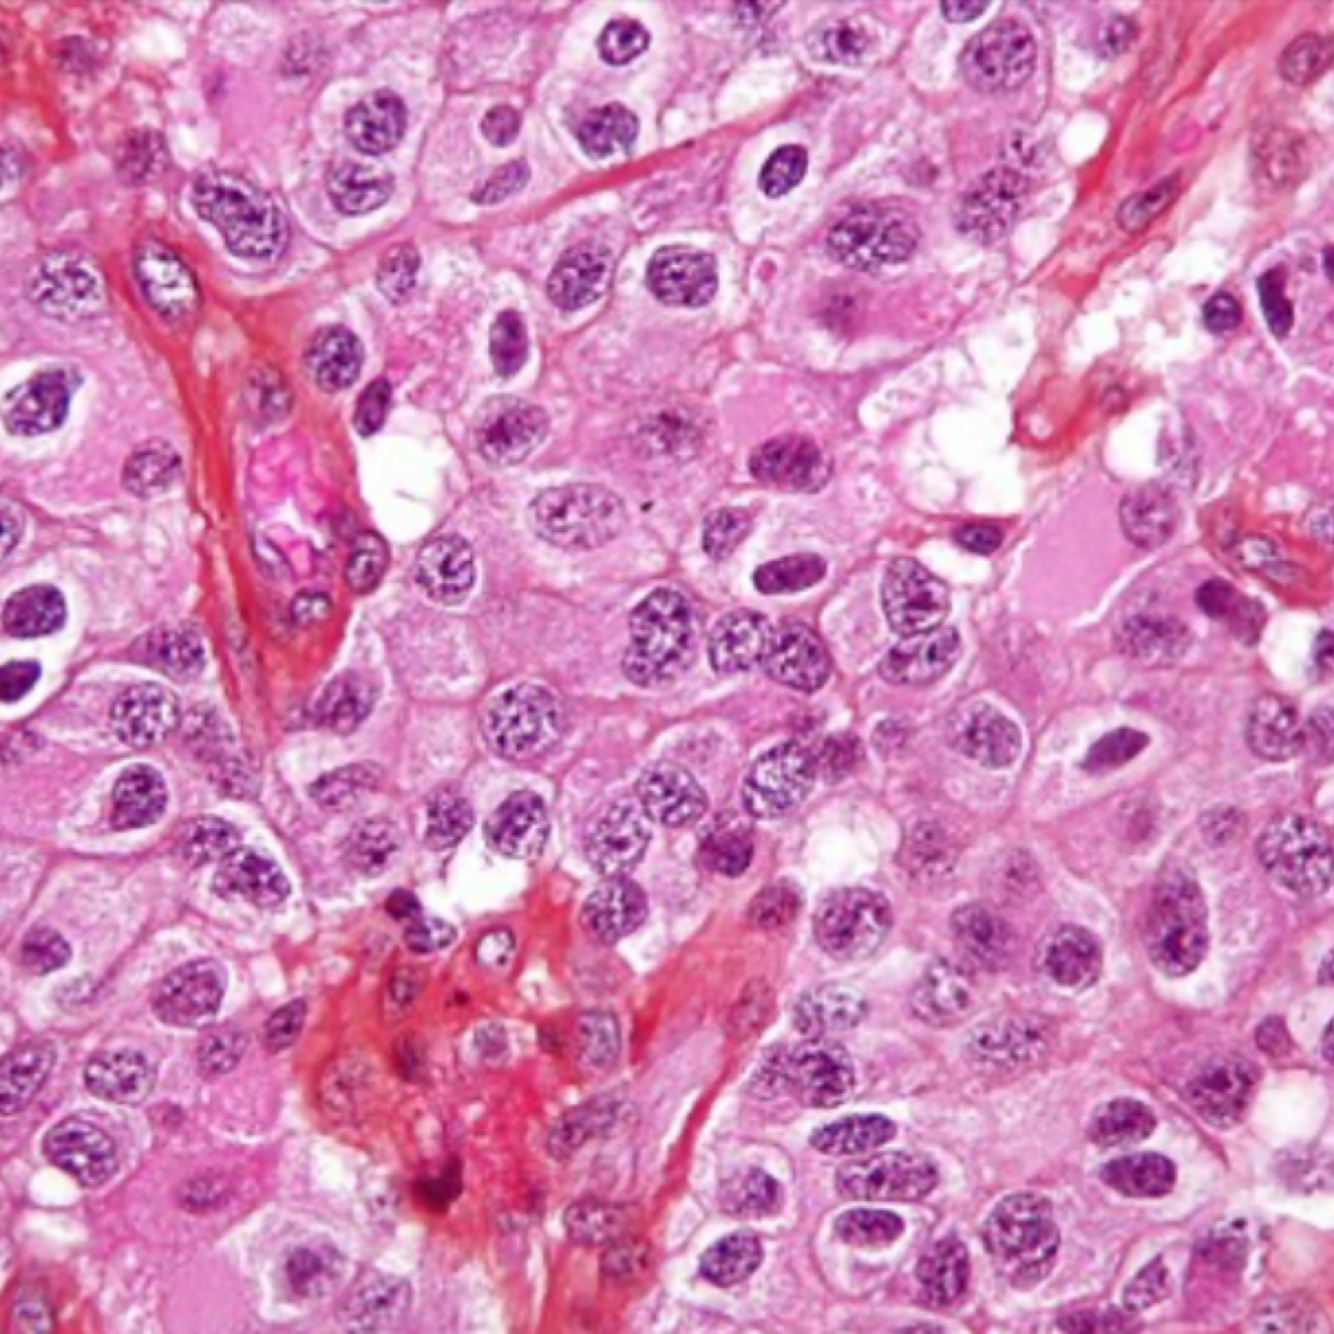

What are common clinical presentations of CNS tumors?
Raised intracranial pressure (headache, seizures), focal neurological deficits.
Why are secondary CNS tumors important to consider?
Secondary tumors can present similarly to primary tumors and are more common in adults.
What is the common CNS tumor in children and where is it located?
Medulloblastoma, typically located in the cerebellum (infratentorial).

What are key considerations in diagnosing CNS tumors in adults?
Metastases should be considered, especially if there’s a history of primary malignancy.
What are the five main locations of CNS tumors?
Meninges, brain parenchyma, ventricles, midline structures, and others (e.g., lymphomas, metastases).
What are the main types of glial tumors?
Astrocytomas, oligodendrogliomas, ependymomas.
What molecular feature helps differentiate types of gliomas?
IDH mutation status (IDH-mutant vs. wild-type).
What are key features of meningiomas?
Originate from arachnoidal cells, commonly slow-growing, associated with NF-2, WHO grade I-III.

How are meningiomas graded?
WHO Grade I (common), II (atypical), and III (anaplastic/malignant).
What is the prognosis for glioblastoma (WHO Grade IV)?
Poor, with a mean survival of less than one year, particularly in IDH wild-type cases.
What is the typical feature of pilocytic astrocytoma?
A WHO Grade I tumor common in children, often with a cystic component.
What genetic mutation defines oligodendrogliomas?
IDH mutation and 1p/19q co-deletion.
What is the appearance of oligodendroglioma cells on histology?
“Fried egg” appearance with uniform round cells.
What is the most common CNS embryonal tumor in children?
Medulloblastoma, aggressive and often spreading via the CSF.
What is a key complication of ependymomas?
Hydrocephalus due to obstruction of CSF flow, often located near ventricles.
What are the two types of choroid plexus tumors?
Papilloma (benign) and carcinoma (malignant).
What are common effects of pituitary adenomas?
Visual field defects (bitemporal hemianopia) and hormonal imbalances due to endocrine effects.

What type of CNS lymphoma is common in immunosuppressed patients?
Primary CNS lymphoma, often driven by EBV.
What is the common site for germ cell tumors in the CNS?
Pineal gland, with a higher prevalence in males.


